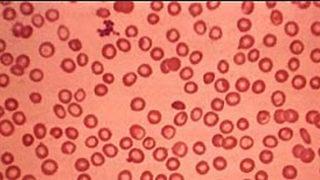
Türkiye'de 4 bin 513 Talasemi hastası var

Akdeniz anemisi talasemi haberleri sayfasında, bu önemli sağlık konusuna dair güncel gelişmeleri ve son dakika haberlerini bulabilirsiniz. Akdeniz anemisi talasemi, genetik bir kan hastalığı olup, özellikle Akdeniz bölgesinde yaygın olarak görülmektedir. Bu hastalıkla ilgili araştırmalar ve tedavi yöntemlerindeki yenilikler, sağlık profesyonelleri ve hasta yakınları için büyük önem taşımaktadır.
Son dönemlerde, akdeniz anemisi talasemi ile ilgili yapılan bilimsel çalışmalar, hastalığın tedavi sürecinde önemli ilerlemeler sağlıyor. Bu sayfada, akdeniz anemisi talasemi konusundaki güncel haberleri takip edebilir, hastalığın belirtileri, tedavi yöntemleri ve toplumsal farkındalık çalışmalarına dair en son bilgileri edinebilirsiniz. Ayrıca, hasta ve ailelerinin yaşamlarını kolaylaştıracak destekleyici bilgileri de güncel olarak sunuyoruz.

Haber Gönder
Haber Gönder